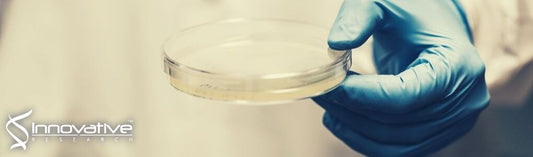
Streptococcus pyogenes Infection and the Human Proteome with a Special Focus on the Immunoglobulin G-cleaving Enzyme IdeS

Product References
Molecular imaging of oxidative stress using an LED-based photoacoustic imaging system
Pooled Human Plasma Apheresis Derived from Innovative Research was used in the following study: Molecular imaging of oxidative stress...
Streptococcus pyogenes Infection and the Human Proteome with a Special Focus on the Immunoglobulin G-cleaving Enzyme IdeS
Pooled Human Plasma Apheresis Derived from Innovative Research was used in the following study: Streptococcus pyogenes Infection and the...
Synthesis of gold nanocluster-loaded lysozyme nanoparticles for label-free ratiometric fluorescent pH sensing: applications to enzyme–substrate systems and cellular imaging
Pooled Human Plasma Apheresis Derived from Innovative Research was used in the following study: Synthesis of gold nanocluster-loaded lysozyme...